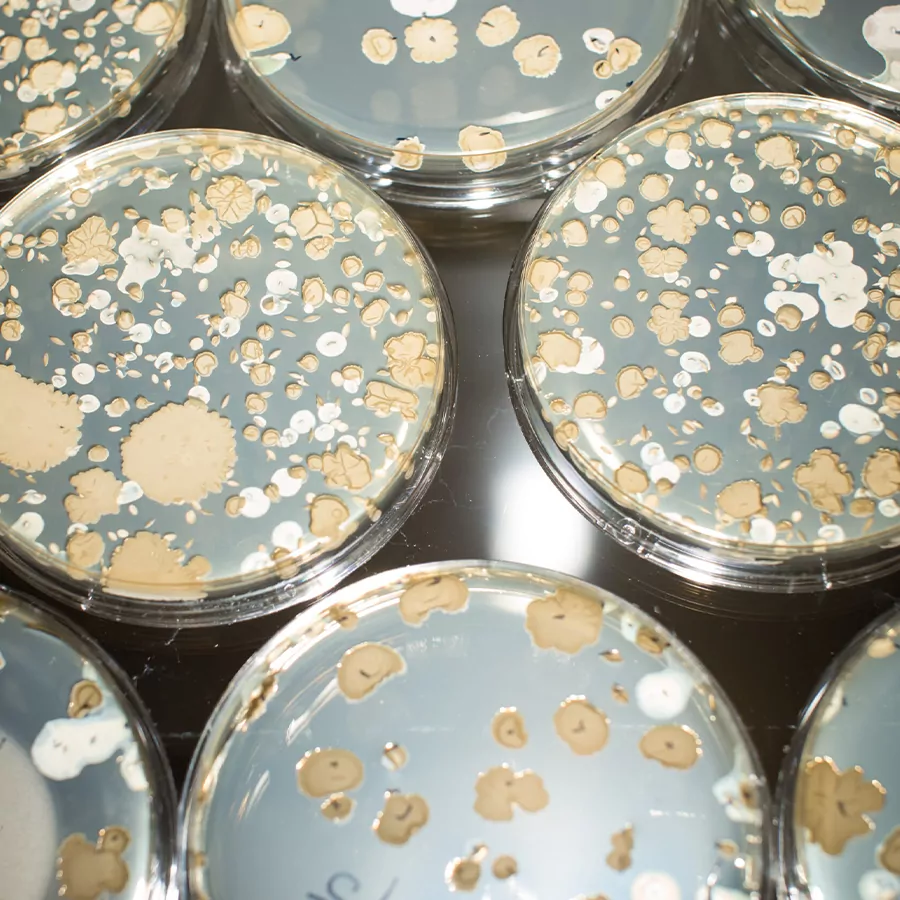

Grow Your Strain with Us!
At MDG, we take pride in the microbial strains we manufacture and grow for our customers. With our dedication to Real Science and a Trusted Process developed over our 20+ years of experience, we deliver Proven Success to our partners. When you choose MDG, you can expect your organism to undergo:
- Isolation: We test for strain purity and ensure that the sample we’ve grown and streaked out in the lab matches your intended strain.
- Optimization: To maximize efficiency throughout the process, we identify optimal growth media and conditions for your organism using our pilot-scale equipment.
- Growth: Our experts create single-strain tanks to ensure only the target organism is present in the final product.
- Commercialization: We specialize in scaling up strains for commercial success, partnering with you along the way to help improve processes and increase yields.
While we’re experts in Bacillus, we can also work with non-Bacillus organisms. No matter what your needs are, we are dedicated to helping you go from strain to sales efficiently, effectively, and economically.
Interested in Custom Fermentation?

We grow Bacillus.
We are a global leader in Bacillus scale-up and manufacturing. When you work through the microbial growth process with us, the quality of our craft shines through. Click the link below to view a video tour of our process and facilities.
Learn More

Fermentation and Manufacturing Capabilities
With our cutting-edge equipment and optimized processes, we can accommodate both the large- and small-scale microbial growth needs of our customers with speed and consistency.
View Our Capabilities
Interested in Custom Fermentation?
Our expertise in custom fermentation affords you the confidence to expect high-quality, consistent Bacillus strain manufacturing delivered with efficiency and integrity.
Application-Specific Programs
We grow Bacillus
We are a global leader in Bacillus scale-up and manufacturing. When you work through the microbial growth process with us, the quality of our craft shines through. Click the link below to view a video tour of our facilities and explore our fermentation, growth, and production processes.
Learn More
Fermentation and Manufacturing Capabilities
Growth &
Manufacturing Capabilities
With our cutting-edge equipment and optimized processes, we can accommodate both the large- and small-scale microbial growth needs of our customers with speed and consistency.
View Our Capabilities
What Sets Us Apart
We Grow Bacillus
We are a global leader in Bacillus scale-up and manufacturing. When you work through the microbial growth process with us, the quality of our craft shines through.
Growth and Manufacturing Capabilities
With our cutting-edge equipment and optimized processes, we can accommodate both the large- and small-scale microbial growth needs of our customers with speed and consistency.
Rapid Scale-Up
Once you have found the perfect strain, the final step to commercialization is scale-up. We have the team and facilities to allow you to scale rapidly, accurately, and economically. From pilot samples to customer trials to manufacturing scale, once you are ready to go to market, we have you covered.
Capacity
With 55,000 liters of large-scale fermentation capability and the downstream processes to match, we can provide our clients with speedy turnaround times, getting your strains out the door seamlessly.
Certifications
We are FSMA-compliant and HACCP-certified for food/feed cultures and products. We also follow Good Manufacturing Practices (GMP) for all production processes, regardless of market. GMP is a core element of FSMA and HACCP. It covers elements like facility design and cleanliness, handling of ingredients and finished products, sanitation, and personal hygiene.
In-House Blending and Packaging
Our growth capabilities are complemented by our extensive in-house downstream processes. This saves our customers time and money by providing various blending and packaging capabilities in-house.
MDG Employees
One of our biggest assets is our people. We are proud to employ an experienced staff that truly cares about our customers and our vision to Feed, Clean, Save the World.
Real Science, Trusted Process, Proven Success
It’s our foundation and our promise. A strong scientific understanding of Bacillus and our optimized microbial growth processes consistently yield measurable success for our customers.
News
Capabilities









